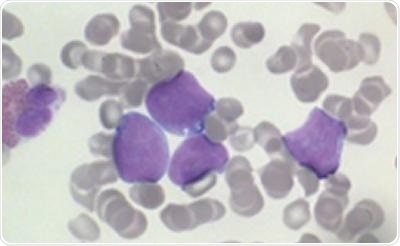

Jul 17 2017
Researchers from the University of Southampton have identified why some people may become resistant to monoclonal antibodies, a common type of immunotherapy used in lymphoma treatment.
Lymphoma cells
Encouragingly, in early studies they have demonstrated that adding an immune response stimulating drug called a ‘STING agonist’ could overcome drug-resistance in this type of blood cancer.
Results from the study, which was funded by the charities Bloodwise and Cancer Research UK, are published in the journal Cancer Research.
The monoclonal antibody rituximab has improved survival rates for many types of lymphoma, but not all patients respond and many will relapse. Researchers in Southampton have been studying how rituximab works and how to overcome resistance. They showed that rituximab works by stimulating specific white blood cells called macrophages, to engulf and “eat” the lymphoma cells.
However, some lymphomas are able to suppress the macrophages by manipulating proteins called Fc-gamma receptors found on their surface to prevent engulfment. The findings help to explain why rituximab can be ineffective in some lymphoma patients.
The researchers then used a series of experimental immune stimulating drugs in combination with monoclonal antibodies to see if they could overcome resistance. In contrast to other immune system stimulators tested, one particular class of reagents called STING agonists were consistently able to stimulate macrophages, reverse the resistance and eliminate lymphoma cells in both mice and human cells in the laboratory when used in combination with monoclonal antibodies.
Dr Stephen Beers, who led the research with Professor Mark Cragg at the University of Southampton’s Faculty of Medicine, said:
We’ve shown that STING agonists can help to “rev-up” immune cells and reverse attempts by the tumor cells to suppress them. There are promising early signs that this approach could be used to improve treatment for people with lymphoma. The next stage will be to modify STING agonists in the laboratory to make them as effective as possible at stimulating the immune system in lymphoma patients.
Dr Alasdair Rankin, Director of Research at the blood cancer research charity Bloodwise, said:
Rituximab has helped to transform survival rates for many types of lymphoma and new ‘next generation’ monoclonal antibodies are improving treatment further, but not all patients will respond. While there is still a while to go before it reaches the clinic, the identification of drug combinations that can overcome treatment resistance could benefit a great many patients.
Professor Peter Johnson, Cancer Research UK’s chief clinician, said:
Antibody treatments to harness the immune system have been one of the great success stories of modern cancer therapy, but we also know that cancers find many ways to escape from the immune system. This exciting research suggests that using drugs to re-programme the cells around a cancer may make antibody treatments much more effective in the future, and we should be able to start testing this in the clinic very soon.
The results build on the University of Southampton's expertise and successful track record in cancer immunology research. Later this year, the University will open the UK's first and only center dedicated to cancer immunology research. The Center for Cancer Immunology will bring world-leading cancer scientists together under one roof and enable interdisciplinary teams to expand clinical trials and develop lifesaving drugs.
The Center, which is based at Southampton General Hospital site, is being funded by a £25 million fundraising campaign by the University of Southampton.